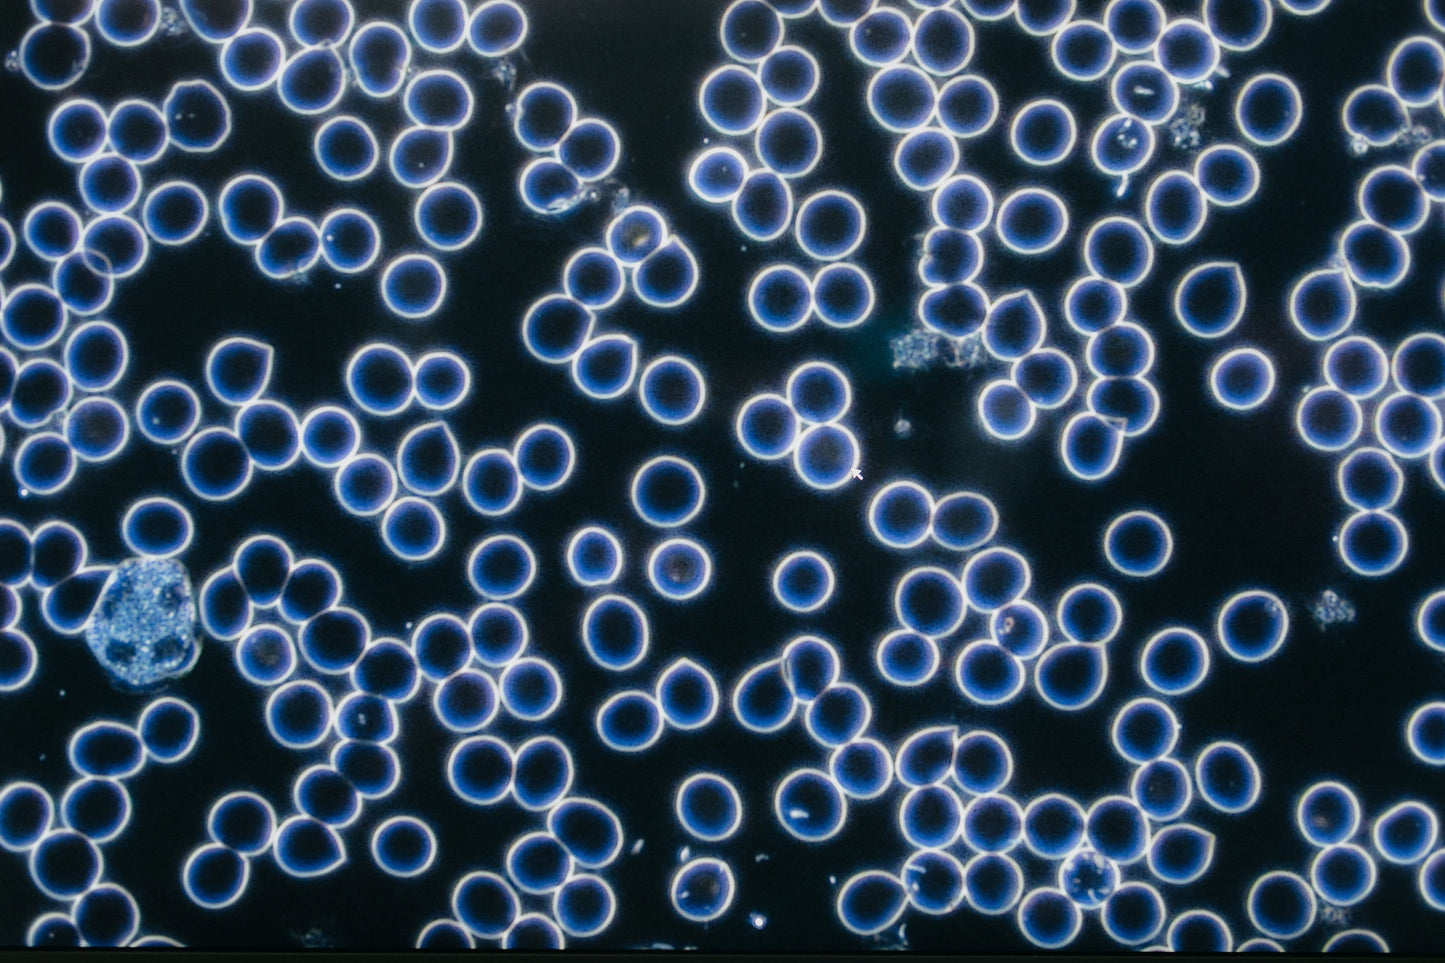
Live Blood & BioEnergetic Testing Follow Up (In-Person)

Unless you address the root cause of an illness you’re not truly healing it.
1
/
of
1
Quantum Leap Natural Medicines
Live Blood & BioEnergetic Testing Follow Up (In-Person)
Live Blood & BioEnergetic Testing Follow Up (In-Person)
Regular price
$200.00 CAD
Regular price
Sale price
$200.00 CAD
Unit price
/
per
A follow-up appointment including Live Blood analysis and a BioEnergetic Muscle Testing Protocol.
Cancellations made less than 24 hours before your appointment may be subject to a cancellation fee.
Share